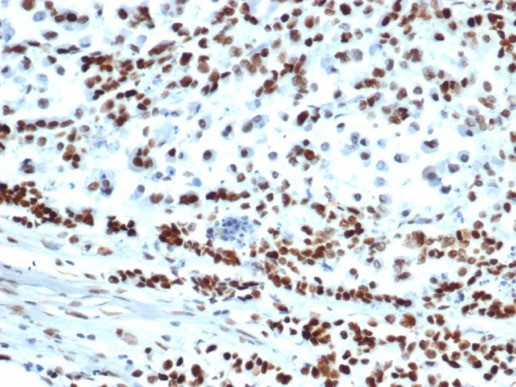
MSH6 (DNA Mismatch Repair Protein) Antibody in Immunohistochemistry (Paraffin) (IHC (P))

Search
NeoBiotechnologies
MSH6 (DNA Mismatch Repair Protein) Recombinant Rabbit Monoclonal Antibody (MSH6/6654R)
{{$productOrderCtrl.translations['antibody.pdp.commerceCard.promotion.promotions']}}
{{$productOrderCtrl.translations['antibody.pdp.commerceCard.promotion.viewpromo']}}
{{$productOrderCtrl.translations['antibody.pdp.commerceCard.promotion.promocode']}}: {{promo.promoCode}} {{promo.promoTitle}} {{promo.promoDescription}}. {{$productOrderCtrl.translations['antibody.pdp.commerceCard.promotion.learnmore']}}
产品信息
2956-RBM14-P0
种属反应
宿主/亚型
Expression System
分类
类型
克隆号
抗原
偶联物
形式
浓度
规格
纯化类型
保存液
内含物
保存条件
运输条件
靶标信息
The DNA mismatch repair MSH2/MSH6 heterodimer is responsible for the detection of DNA damage, and may promote apoptosis in normal cells, thus protecting mammals from ultraviolet-induced malignant transformation and hence the prevention of skin cancer.
仅用于科研。不用于诊断过程。未经明确授权不得转售。
篇参考文献 (0)
生物信息学
蛋白别名: DNA mismatch repair protein Msh6; G/T mismatch-binding protein; GTBP; hMSH6; mutS (E. coli) homolog 6; MutS alpha 160kDa subunit; MutS protein homolog 6; MutS-alpha 160 kDa subunit; MutS-alpha 160kDa subunit; mutS-like protein 6; p160; Sperm associated protein; sperm-associated protein; unnamed protein product
基因别名: GTBP; GTMBP; HNPCC5; HSAP; LYNCH5; MMRCS3; MSH-6; MSH6; p160
UniProt ID: (Human) P52701
Entrez Gene ID: (Human) 2956, (Dog) 474585